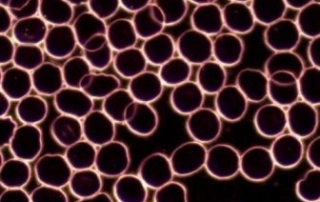
livebloodcell 320x202 1

How Can Massage Therapy Influence Immune System Health?

By Jennifer Hyland, RMT As we move into cold and flu season, everyone is looking for a way to stay germ free. In some cultures, massage is a traditional way to prevent colds, or to manage symptoms when a cold first starts. While I don’t recommend a massage when you’re all-the-way sick, we have research […]
“Leaky Gut” – A Key Factor in Inflammation & Autoimmune Disease

By Dr. James Yoon, ND “Leaky Gut” – A Key Factor in Inflammation and Autoimmune Disease Have you noticed a connection between what you eat and how you feel? We know that the foods we eat can have a profound impact on our health, but research is showing that our gut health – and […]
Back-to-School Balance

Back-to-School Balance By Nindy Grewal, Holistic Nutritionist, Live Blood Cell Analyst Tips for Surviving a Healthy School Year We are now winding down on summer and preparing for a new school year, both can bring about feelings of excitement and anxiousness. As parents, we are ready for the kids to be back on track […]
Does Massage help during Pregnancy?

By Deborah VanderKruk, RMT The pregnancy test comes back positive. A deluge of emotions ensues. Our responses may range from exhilaration and relief to anxiety and fear. We embark on the journey of preparing for a little one, navigating information overload, unsolicited advice, and loads of marketing. For some women, having regular massages […]
I Named My Eating Disorder: Ariel’s Story

INFORMATION Ariel is a 17-year-old girl who battled anorexia. Her name has been changed to protect her identity. I named my eating disorder Ursula, the villain from my favourite childhood movie ‘The Little Mermaid’. In many ways, my anorexia had presented characteristics that I saw in Ursula. Anorexia – Ursula – is devious, manipulative, and […]
Getting to Know Your Practitioners Better Featuring Dr. Lisa Adams

How did you get into your current career/what made you decide to pursue this career? As I was studying biology and nutrition and trying to find my own best health, I found there were gaps in the conventional system where myself and others were not getting the help they needed to prevent disease, […]
Is Massage Therapy Good for Runners?

By Jen Hyland, RMT Runners are going to run, whether they should or shouldn’t. As the daughter of a marathoner, I grew up watching my dad peel off blood soaked socks and shoes for years before he finally figured out his footwear. For some reason, this made me think that all runners were […]
Parasites and Live Blood Analysis
By Nindy Grewal Winter getaways are definitely the best reprise from our harsh winter months. Tropical islands, Asian destinations, visits back to home countries can provide that sunshine and warmth, plus stress relief that we so greatly need after being stuck in the house during cold, dark months of the year. However, have you ever […]
Adjusting from the Winter “blah’s” to the Spring “ahh’s”…Mentally, Emotionally, Physically

By Trudy Parolin Let’s face it, Canadian winters can be exceptionally difficult for most of us on the best of days. The -17 windchill factors, the blowing snow, ice, the feeling of being cold, and then of course those gloomy days. It affects us all in so many ways. I think we had a whopping […]
Does Hot Stone Massage Really HELP?

By Jen Hyland, RMT If you like heat, it won’t take any convincing for you to believe that a hot stone massage will feel amazing. If you’ve had a hot stone massage, you felt warm, your muscles relaxed, your nervous system calmed down, and it probably didn’t feel like the therapist was working […]